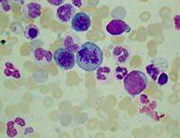

Американские ученые разработали новый метод лечения ряда врожденных заболеваний, основанный на использовании стволовых клеток. В отличие от предыдущих работ, на этот раз исследователи доказали его эффективность не только в лабораторных условиях, но и в реальной клинической практике.
Как сообщает "ВВС", специалисты из Университета Дьюк (США, Дьюрем) испытали предложенный ими метод при лечении ряда врожденных заболеваний сердца, печени и головного мозга. Общие результаты оказались положительными - введенные в кровь стволовые клетки внедрялись в больные ткани и восстанавливали их функции. Однако исследователи так и не смогли разобраться, можно ли как-то управлять этим процессом, а также выработать какие-либо конкретные рекомендации по оценке его эффективности.
Напомним, что использование стволовых клеток сейчас считается одним из наиболее перспективных направлений развития медицины. За последние десятилетия было проведено несколько сотен исследований возможностей этого метода, однако пока ни один из них не нашел реального применения.
AskDoctor.ru